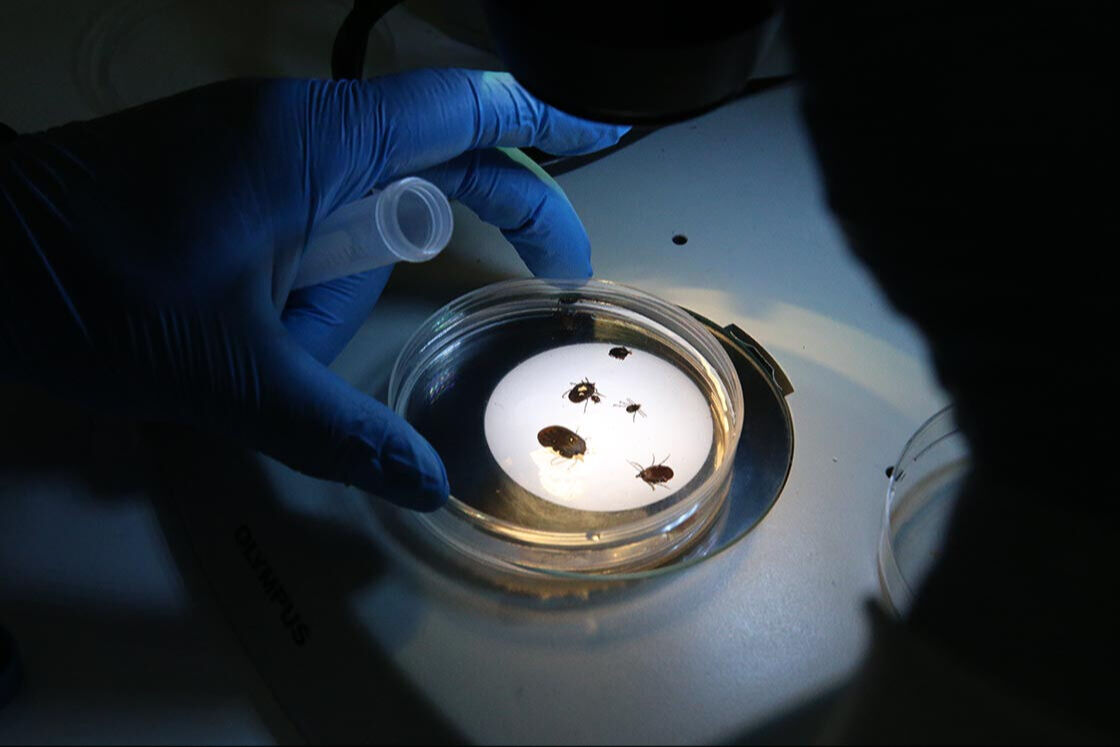
Zehirli kene nasıl anlaşılır? KKKA virüsünün insanlara bulaşma yolları neler? Zehirli kene nasıl anlaşılır? Zehirli kene ısırmasının belirtileri neler? - 3. Resim

Zehirli kene nasıl anlaşılır? KKKA virüsünün insanlara bulaşma yolları neler?

Ülkemizde üst üste yaşanan kene kaynaklı ölümler büyük bir endişeye neden oldu. Özellikle kırsal alanlarda etkisini arttıran vakalar, Kırım Kongo Kanamalı Ateş (KKKA) tehdidini bir kez daha günyüzüne taşıdı. Sağlık Bakanlığı vatandaşları kenelere karşı dikkatli olması gerektiği konusunda uyardı.
2002-2024 yılları arasında 819 kişinin hayatını kaybetmesine sebep olan Kırım Kongo Kanamalı Ateşi (KKKA), havaların ısınması sebebiyle yeniden gündeme geldi.
Türkiye'nin farklı noktalarıda art arda görülen vakalar ve ölümler, vatandaşlarda tedirginliğe sebep olurken, uzmanlar kene teması. hakkında peş peşe uyarı yapmaya başladı. Peki, Zehirli kene nasıl anlaşılır? Zehirli kene ısırmasının belirtileri neler? İşte tüm ayrıntılar...

KKKA VİRÜSÜNÜN İNSANLARA BULAŞMA YOLLARI NELER?
Sağlık Bakanlığı tarafından Kırım Kongo Kanamalı Ateşi Vaka Yönetim Rehberi paylaşıldı. Buna göre, KKKA virüsünün insanlara bulaşma yolları arasında başlıca şu belirtiler vardır.
- Enfekte doymuş kenelerin (özellikle doymuş dişilerin) çıplak el ile çıkarılması
sırasında, kene bağırsak içeriği ile korunmasız temas, - Viremik hayvanların kan, doku ve sekresyonları ile korunmasız temas,
- KKKA hastalarının kan ve diğer vücut sıvıları ile korunmasız temas,
- Kan içeren damlacık yolu ile bulaşma (aspirasyon, resüsitasyon ve öksürme vb.
esnasında)
ZEHİRLİ KENE NASIL ANLAŞILIR?
Sağlık Bakanlığı ve Halk Sağlığı Genel Müdürlüğü'ne göre, "zehirli kene" ibaresi yerine, Kırım Kongo Kanamalı Ateşi virüsü taşıyabilecek enfekte kene kavramı kullanılmıştır.
Kenenin görüntüsüne bakılarak zehirli olup olmadığı ya da virüs taşımadığını anlamak mümkün değildir. Tüm keneler potansiyel taşıyacı olabilir. Bu nedenle her kene zararlı olabilir. Vücuda yapışan bir kene fark edildiğinde mutlaka çıkartılmalıdır.
Kene ne kadar erken çıkarılırsa hastalığın bulaşma riskinin de o kadar azdır. Ayrıca hastalığa yakalanan kişilerin kan, vücut sıvıları ve çıkartıları ile hastalık bulaşabildiğinden, hasta ile temas eden kişiler gerekli korunma önlemlerini (eldiven, önlük, maske v.b.) almalıdır.






